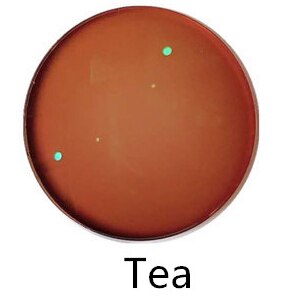

SHINU Photochrome Brille Titanrahmen - Blue Ray Filter, UV400, Für Männer & Frauen
Sehr beliebt
lieferbar - in 1-2 Werktagen bei dir
13 €
inkl. MwSt. zzgl.
Versandkosten
Artikelbeschreibung